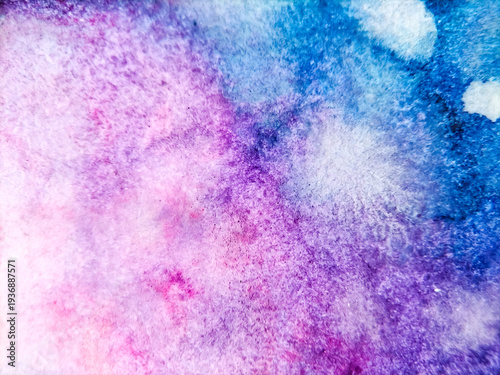

Abstract watercolor painting features a gradient blending of vibrant colors, primarily pink, purple, and blue.
Schlüsselwörter
abstract,
art,
artistic,
background,
bright,
brush,
canvas,
colours,
colourful,
creative,
decoration,
decorative,
design,
drawing,
element,
graphic,
grunge,
illustration,
paint,
paper,
pattern,
splash,
texture,
textured,
vintage,
wall,
wallpaper,
watercolor,
grimy,
blank,
painting,
closeup,
rough,
surface,
material,
colours,
closeup,
background,
ancient,
detail,
template,
creativity,
natural